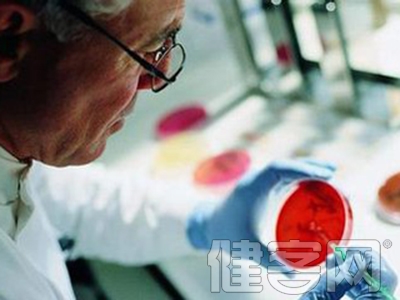
肿瘤筛查针对才有效

防癌体检是指在健康状况下或没有任何症状的情况下,进行的一系列有针对性的医学检查,这些检查方法有助于发现已存在身体中的、早期或可治愈期的肿瘤。那么癌症筛查到底哪种才是最有效?
B超
适用:可以很清楚地看到腹部肿瘤,如肾癌、肝癌,盆腔内肿瘤,如子宫内膜癌、盆腔癌、卵巢癌等,可判断乳腺、颈部肿物的位置、大小、鉴别其良恶性。
检查频率:健康人一年检查一次。对于乳腺癌,40岁后就该每年做一次钼靶结合B超的筛查,35岁以下的女性更应首选B超。
注意事项:做消化道超声前3天最好禁食牛奶、豆制品等易发酵产气的食物;检查前1天晚上吃清淡饮食;当天检查前需空腹,禁食禁水;做盆腔超声前需保留膀胱尿液,可在检查前2小时饮1000毫升左右开水,检查前2—4小时别小便。
X线检查
适用:目前比较常用的是肺癌筛查,即胸部螺旋CT检查和乳腺癌筛查。
检查频率:中老年人,尤其是嗜烟者,应列为肺癌重点普查人群,每半年至1年检查1次。50岁后可每年做一次乳腺X线筛查。
注意事项:尽量减少受照量,最好仅暴露被检部位,尽量减少曝光时间。此外,婴幼儿、孕妇、有生小孩打算的青年女性应远离。
内镜
适用:肠癌、胃癌
检查频率:40岁后,建议去做一次胃镜检查,可将胃癌扼杀在早期萌芽中。特别是胃癌的高危人群,如慢性萎缩性胃炎、胃溃疡以及有胃癌家族史者,更应每年做一次检查。而从大肠腺瘤发展到大肠癌通常需要5—10年时间,因此筛查很有必要。50岁后,应每年查次大便隐血试验,5年查次肠镜,家里若有亲属患肠癌,最好从40岁开始。
注意事项:检查前三天宜吃无渣或少渣半流质饮食,不吃果蔬,检查当天早晨禁食早餐。
抽血
适用:现在一般常规体检中都有肿瘤标记物检查,此外,前列腺的筛查,普遍采用的方法是抽血查前列腺特异抗原(PSA)。
检查频率:肿瘤标记物最好每年查一次;50岁以上的男性都该在体检时检查PSA,每年一次,如有异常,应复查两三次,排除炎症的可能。
注意事项:如果标记物数值异常,有可能提醒肿瘤的存在,应进一步做CT、B超明确诊断。
宫颈涂片检查
适用:宫颈癌
检查频率:初次房事后的三年可每年做次宫颈涂片检查。30岁后可依据风险因素检查,如果三次或多次结果连续为阴性,可以减少受检次数。
注意事项:检查最好躲开月经期,如果有妇科急性炎症或感染,最好等病愈后再做,计划检查前24—48小时内不要冲洗阴道。
(实习编辑:王欢)
扫描上面二维码在移动端打开阅读